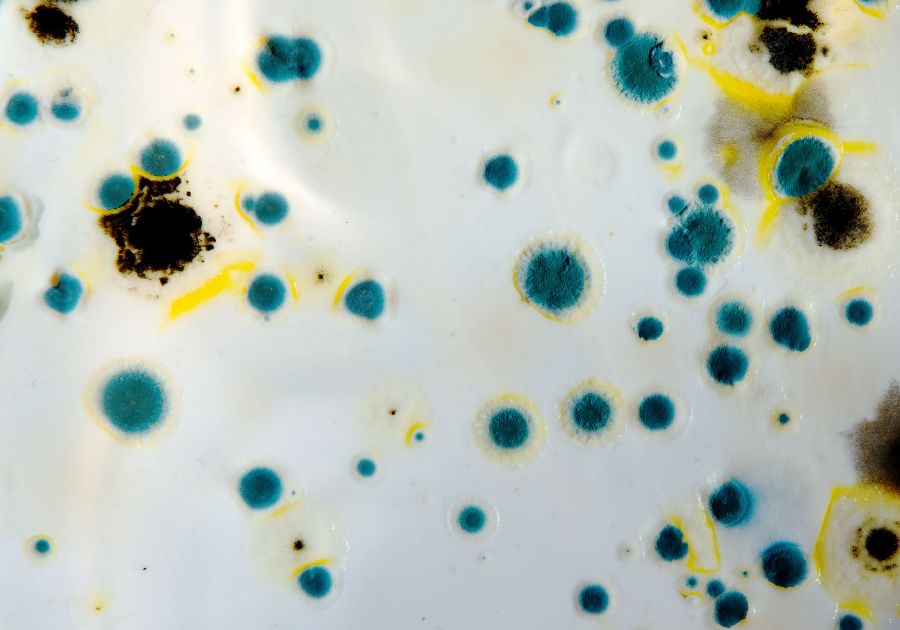

サマリーポケットの利用を考える上で、気になるのがカビ対策。
サマリーポケットに物を預けたら、カビが生えてしまったという噂もチラホラ耳にすることも。
私も、様々な宅配型トランクルームを利用しているので、気になります。
本当に、サマリーポケットに物を預けて大丈夫なのか、実際に検証してみました。

・元ミニマリスト(収納家)
結婚、出産で家の中が大混雑
溢れかえった物でストレスを抱える
トランクルームを使い家の中がスッキリ
ストレスフリーで執筆中
当記事の結論

実際に、荷物を預けてもカビは生えませんでした
\ 秋冬スッキリ応援キャンペーン中 /
最大4ヶ月無料



サマリーポケットに関する他の気になる口コミも調べました


当ブログおすすめ記事
≫【2025年】宅配型トランクルーム23社を比較『おすすめ』はココ!


サマリーポケットに預けたらカビが生えた!?

サマリーポケットに、物を預けたらカビが生えた!という噂は本当なのか検証しました。



まずは、なぜそのような噂が出回ったか調査してみたよ
サマリーポケット カビという検索ワードについて
サマリーポケットと検索すると、続けてカビというワードが出てきます。


この検索ワードは、気になる人が多く月に260回も検索されていることがわかりました。





確かに気になる検索ワードだよね



カビが生えるなら絶対利用したくない
なぜ、このような『サマリーポケット カビ』という検索ワードが出るのか調べました。
事の発端は、1つのによる投稿でした。
サマリーポケットに衣類を預けてカビが生えたという投稿
『サマリーポケット カビ』の発端となった投稿
この投稿を見た人が、『サマリーポケット カビ』でGoogle検索したのが発端と予想されます。
その後は、検索窓に予測変換で出てくるようになり、利用を考えている人が数珠つなぎで検索している模様。



負の連鎖ともいえる症状だね
その他にも、カビの報告が多数







これだけカビの報告があると利用は控えたくなるね
この投稿だけでは、サマリーポケット側の責任なのか、利用者側の責任なのかわかりません。
他の宅配型トランクルーム『minikura』『AZUKEL』では、カビが発生した報告が全くないのも事実です。



実際に衣類を預けてみて、本当にカビのリスクがあるのか調べてみたよ
実際にサマリーポケットを利用してみてカビは生えた?


実際にサマリーポケットに物を預けて、カビが生えてしまうのか検証しました。



本当にカビが生えるほど保管環境は悪いのか調べてみたよ
衣類を預ける時の状態


預ける服は、一度家で洗濯をした後、部屋干ししたものを預けました。
クリーニングや無酸素保管オプションなどは付けず、シンプルに預けることにしました。





預ける期間は5月から10月までにしました
衣類を取りだした時の状態
約5カ月間預けて取り出した衣類たちの状態


カビも生えていないし、カビ臭さも全くしなかった。



全くカビの心配はないという結果になったよ



じゃあなんでカビが生えた報告があったんだろう?
実際に預けてみてカビが生えた原因を考察
私の推測になりますが、カビが生えた理由は、預ける前の状態に原因があった可能性が高いと思います。
- 預ける前に衣類に少量のカビが生えていた
- 半がわきの状態で預けてしまった
- 梱包に隙間が生じていた
サマリーポケットは倉庫環境を徹底しているので、サマリーポケット側の不備でない可能性が高い。



サマリーポケットはカビが生えにくい環境を整えています


\ 秋冬スッキリ応援キャンペーン中 /
最大4ヶ月無料



サマリーポケットのカビに関する心配が解決したら、他の口コミも見てみよう


サマリーポケットに預けた物にカビが生えないための予防策


- 預ける前に洗濯、清掃する
- しっかりと乾かしてから梱包する
- 梱包を隙間なく行う
- 除湿剤・防虫剤を入れておく
- 無酸素保管オプションを利用する



これさえしっかり守れば、カビが生える心配はないよ
物を預ける前に洗濯、清掃する
預ける前に洗濯したり、除菌シートで拭いておきましょう。
カビの元が付着した状態で預けてしまっては、いくらサマリーポケットの倉庫環境が良くてもカビが繁殖してしまいます。
荷物はしっかり乾かしてから梱包する
荷物が濡れた状態で、ダンボールに梱包してしまうと、ダンボール内の湿気が高くなってしまいます。
湿気が高い状態では、カビの発生するリスクが高くなってしまいます。
梱包は隙間なく行う
梱包に隙間が生じていると、運送中に湿気やカビの元が入り込むリスクが高くなります。





こんな感じでしっかり梱包してみよう



箱崩れのリスクも軽減されるね
除湿剤・防虫剤を入れておこう
上記の3点をしっかり行ってもまだ不安な人は、念のために除湿剤・防虫剤を入れておこう。
無酸素保管オプションを利用する




大事な服を保管する場合は、無酸素保管オプションを利用してみましょう。



通常よりさらに良い環境で保管してくれる
\ 予防策をしっかりすればカビは生えない /
家で保管するよりカビのリスクは少ない
サマリーポケットのカビに関するよくある質問


- カビが発生したときは補償してもらえますか?
-
カビなどの自然劣化、預ける前からの汚れや湿気
こういった原因がユーザー側にある場合は補償対象外となる可能性があります。 - カビが発生しやすいアイテムは?
-
以下のようなアイテムは特に注意が必要です:
- 革製品(バッグ・財布など)
- 衣類(湿ったまま預けると危険)
- 本・紙類
- 布製のおもちゃ・寝具
- 楽器(木材部分)
- カビが発生してしまったらどうすればいい?
-
倉庫の管理状況が疑わしい場合はサポートへ連絡
証拠としてカビが生えた状態を撮影しておきましょう
サマリーポケットのカビに関する検証結果
今回、実際に衣類を預けてみましたが、カビが生える心配は感じませんでした。



預ける前の状態をキレイにしておけば、カビが発生するリスクは少ないよ
ただし、他の宅配型トランクルーム『minikura』『AZUKEL』では、カビが発生した報告が全くないのも事実です。
それでも心配な人は、カビの報告があがっているサマリーポケットよりも、『minikura』や『AZUKEL』を利用したほうが良いかもしれません。



他の宅配型トランクルームが気になる人は、下記の記事を参考にしてね
当ブログおすすめ記事
≫【2025年】宅配型トランクルーム23社を比較『おすすめ』はココ!






